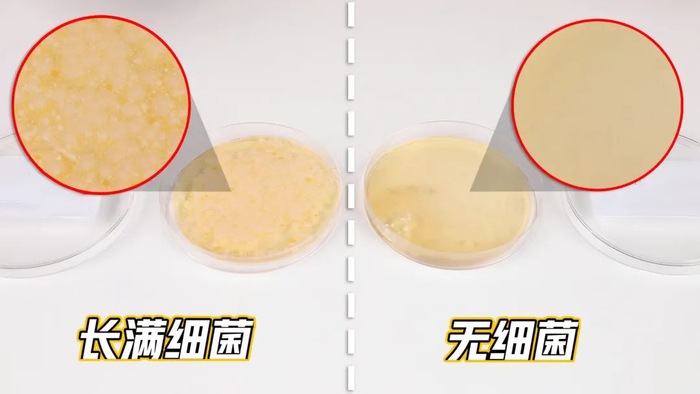

在日常生活中,谁都免不了碰上要脱鞋的情况。
脱鞋不可怕,可怕的是脚臭;那味道集酸、臭、咸于一体,不仅刺鼻,还有点辣眼睛。
其实,让自己尴尬,让旁人窒息的脚臭味,都是因为脚上有着超过25万个汗腺,每天分泌的汗液可以装小半瓶水。
这些汗液皮屑闷在袜子里,让真菌和细菌大量繁殖,就有了让人当场去世的酸臭味。
所以为了尽可能避免这种情况的发生,有一双能够吸汗排汗还能抗菌的袜子就十分必要。
隐形盾男士抗菌防臭袜,精选了阿塞拜疆长绒棉,保证了袜子拥有了良好的吸汗透气性,与此同时还特别添加了美国陶氏银离子抑菌技术,减少了细菌的产生,双管齐下,让脚臭离你远远的。
推荐理由
1、美国陶氏银离子抑菌技术,抑菌率高达99%
2、德国速干技术,吸湿排汗,穿7天不臭脚
3、阿塞拜疆长绒棉,300天日照孕育,亲肤柔软
4、杜邦莱卡弹性纤维,弹力十足,不变形不勒脚
5、隐形盾品牌的国家专利超过90项,防臭袜有6项国家专利,赞助多届奥运会、亚运会
吸汗、透气、速干
3管齐下,穿7天不臭脚
不知道你有没有发现,平时穿着穿尼龙袜子或者普通棉袜再穿上不怎么透气的鞋子的时候,一脱鞋简直就是生化武器。
想要不臭脚先得看袜子的面料。隐形盾抗菌防臭袜采用的是阿塞拜疆长绒棉。
这种棉花生长在戈壁上,经过300多天的阳光洗礼,它们纤维柔长,洁白且富有光泽,弹性也十分好。
最重要的是用这样的棉花织成的袜子,拥有良好的吸湿性。
用水来模拟汗液,滴在袜子上,可以看到只需要1秒,水就被吸收掉了。
与其同时它的透气性也值得称赞。加湿器的水雾也能够1秒穿透袜子,没有任何阻隔。
良好的吸湿透气性能就能够让脚步的汗液快速吸收并排出,从而减少细菌的繁殖生长。
光是吸汗透气还远远不够,隐形盾抗菌防臭袜还引用了德国鲁道夫ICE-FINISH速干技术。
也就是说在脚部排出汗液时,良好的吸湿性能将汗液快速吸收,并迅速将汗液传导至袜子表面快速蒸发,让双脚和袜子保持干爽。
抑菌率高达99%
洗涤50次除臭效果依然强悍
除了从面料上让你远离脚臭,隐形盾抗菌防臭袜还应用美国陶氏银离子抑菌技术。
这种技术能够抑制袜子上的细菌繁殖,从而减少细菌引起的变质、变味。
有检测报告证明,对于常见的三大菌种:大肠杆菌、金黄色葡萄球菌、白色念球菌都有很好的抑制作用,AAA级抑菌率高达99%以上!
而且,即使洗涤50次之后,抑菌率仍然高达99%!看吧,除臭能力不仅强悍,而且持久!
这次,只要将袜子穿在脚上,就能把鞋内的大部分细菌杀死,想产生臭味都很难。
我们也简单做了一个小实验,分别在穿过普通棉袜和隐形盾袜子上分别提取少量纤维放入培养皿中。
两天后,普通棉袜的培养皿中长满细菌,而隐形盾防臭袜的培养皿中几乎没有细菌出现。
※左为普通棉袜;右为隐形盾防臭袜
这样一来,隐形盾从面料到技术双管齐下,抑菌和防臭效果相当给力!
柔软舒适弹性十足
穿上感觉一脚踩进云朵里
在穿这双袜子之前,我是不相信原来袜子之间的区别会这么大的。
阿塞拜疆长绒棉纺织而成的袜子柔软舒适,上脚的感觉简直就像一脚踩在了云朵上。
采用了无感缝合技术使得袜身平滑无痕,不管是袜子头还是袜子跟都找不到一丝多余的线头。
上脚没有任何凸起的不适感。立体的袜跟也跟加贴合我们的脚型,脚感杠杠滴。
我穿了一周还有一个感受,就是穿着宽松不勒脚但袜子也不会跑。
普通的袜子弹性小,穿在脚上经常会在脚踝处勒出红印。
但隐形盾抗菌防臭袜添加了美国杜邦莱卡纤维,使得整双袜子的弹性增强。
一拽就知道弹性是真的大,这样的袜子穿在脚上就两个字:舒服!
穿上一整天也不会勒脚,特别舒服。
船袜款式也能穿得很牢靠,即使用力抻拽也不会掉跟,就跟长在脚上一样服帖~
除了舒适,隐形盾的袜子还十分百搭。
搭配运动鞋就是阳光运动大男孩儿~
搭配皮鞋就是都市休闲精英范儿。
夏天穿船袜,隐形效果也非常优秀,完全不会露出来。
2020东奥会合作伙伴
穿过的人都说好
之所以能生产出这样好穿的优质袜子,是因为每一双袜子都是由隐形盾自有工厂生产出来的。
他们拥有新一代200针织袜机、全自动缝头机,还有来自韩国的三德全自动定型机,可见为了产出一双足够舒适的袜子,隐形盾对设备的要求十分高。
除了对设备的用心,隐形盾还自主研发、自己设计、独立生产,这样专业的制袜企业生产出来的袜子就让人十分放心!
隐形盾曾登入NBA常规赛、里约奥运会、国际乒联世界巡回赛、亚运会等大型赛事的赛场,同时也是2021年东京奥运会、2022年北京冬奥会的赞助商。
更是得到了央视的认可,成为央视网商城的优选品牌。不仅如此,作为阿塞拜疆奥委会的官方合作伙伴,也是2021年东京奥运会、2022年北京冬奥会的赞助商。
而且品牌实力非凡,得到了超过90个国际专利。今天推荐的抑菌袜就获得了6个专利。
除了来自官方的认可,穿过这双袜子的人也都是一水儿的好评!
这一次给大家带来的款式也非常多。